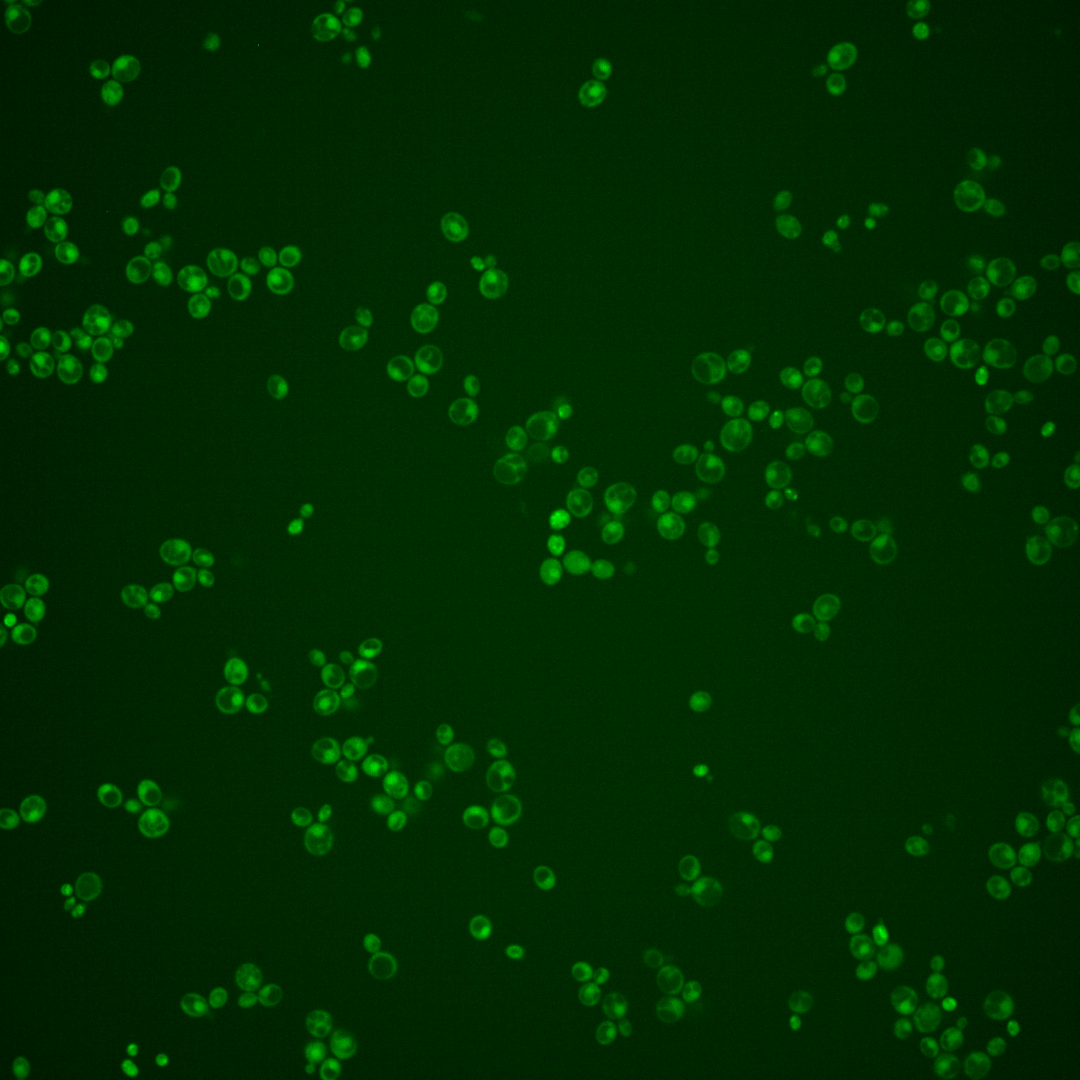
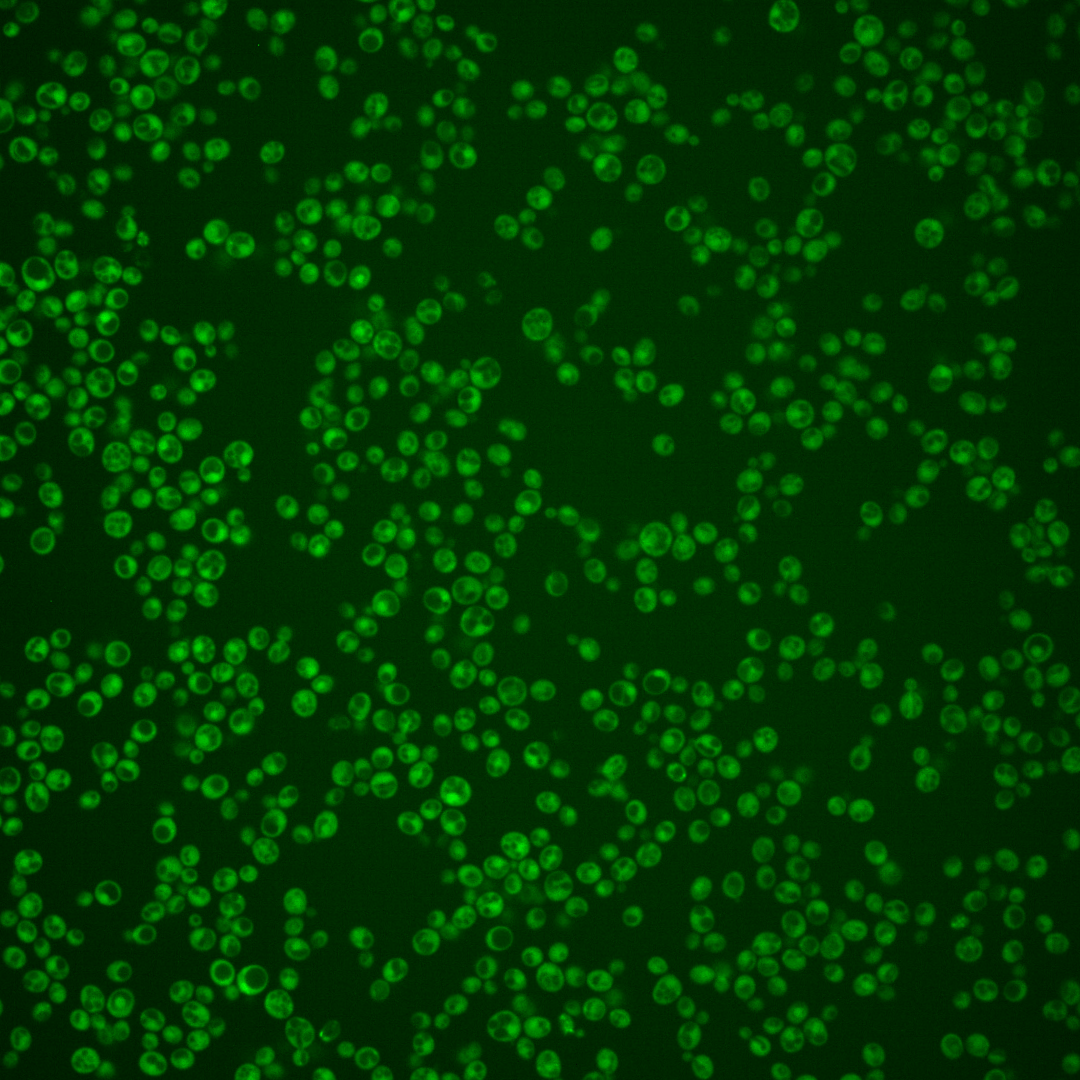
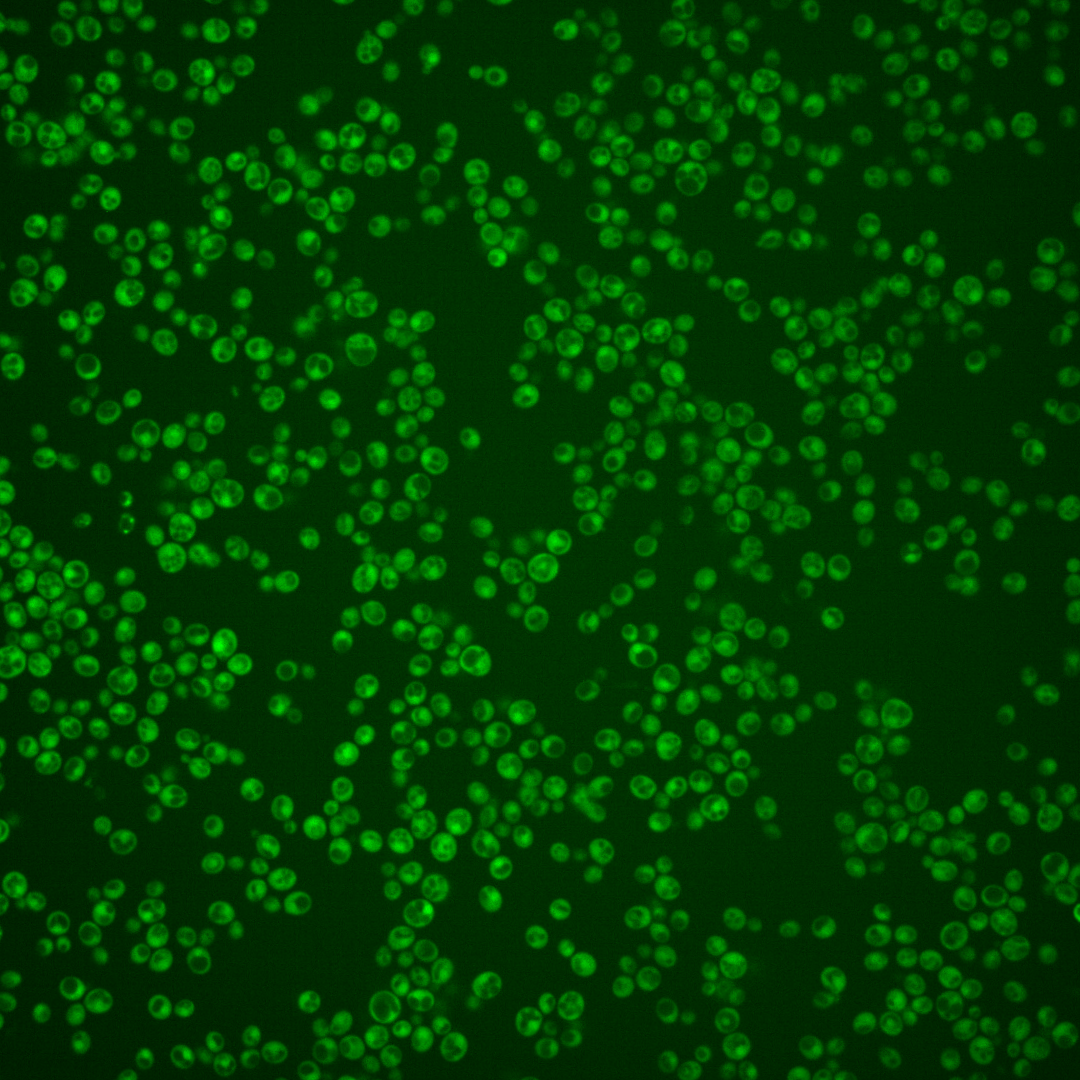
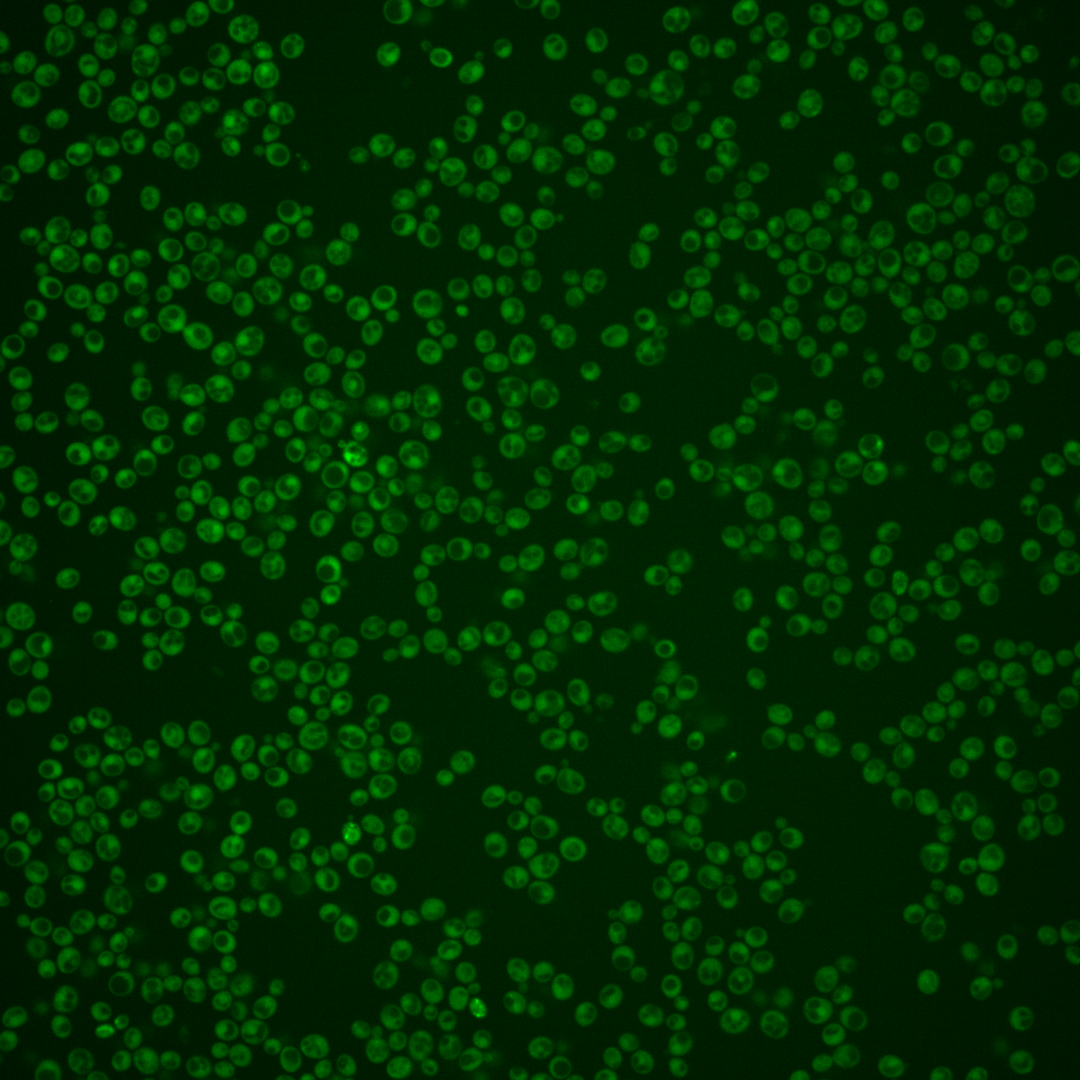

| Standard name | |
|---|---|
| Human Ortholog | |
| Description | Nucleoside monophosphate and nucleoside diphosphate kinase; functions in the de novo biosynthesis of pyrimidine deoxyribonucleotides; thymidylate/uridylate kinase that converts nucleoside monophosphates, dTMP and dUMP to nucleoside diphosphates, dTDP and dUDP; nucleoside diphosphate kinase that converts nucleoside diphosphates, dTDP and dUDP to dTTP and dUTP; essential for mitotic and meiotic DNA replication; homologous to S. pombe tmp1; human homolog DTYMK can complement the cdc8 null mutant |
Micrographs




















































































Sub-cellular Localization
Yeast GFP Assignment
Protein Abundance
Localization Change
External localization resources
| ensLOC | DeepLoc | |||||||||||||||||||||||
|---|---|---|---|---|---|---|---|---|---|---|---|---|---|---|---|---|---|---|---|---|---|---|---|---|
| Localization | WT1 | WT2 | WT3 | RAP60 | RAP140 | RAP220 | RAP300 | RAP380 | RAP460 | RAP540 | RAP620 | RAP700 | HU80 | HU120 | HU160 | rpd3Δ_1 | rpd3Δ_2 | rpd3Δ_3 | WT1 | WT2 | WT3 | AF100 | AF140 | AF180 |
| Cortical Patches | 0 | 0 | 0 | 0 | 0 | 0 | 0 | – | 1 | 1 | 0 | 1 | 0 | 0 | 0 | 0 | 0 | 0 | 2 | 1 | 1 | 1 | 1 | 1 |
| Bud | 0 | 0 | 0 | 0 | 0 | 3 | 2 | – | 6 | 3 | 4 | 13 | 0 | 0 | 0 | 0 | 0 | 0 | 0 | 2 | 3 | 0 | 8 | 4 |
| Bud Neck | 0 | 0 | 0 | 0 | 0 | 0 | 0 | – | 0 | 0 | 1 | 0 | 0 | 0 | 0 | 0 | 0 | 0 | 0 | 0 | 0 | 0 | 1 | 1 |
| Bud Site | 0 | 0 | 0 | 0 | 0 | 0 | 0 | – | 0 | 0 | 1 | 1 | 0 | 0 | 0 | 0 | 0 | 0 | – | – | – | – | – | – |
| Cell Periphery | 1 | 2 | 7 | 1 | 2 | 1 | 7 | – | 4 | 4 | 5 | 9 | 0 | 1 | 2 | 6 | 6 | 4 | 0 | 0 | 0 | 0 | 0 | 0 |
| Cytoplasm | 169 | 237 | 422 | 277 | 335 | 310 | 429 | – | 430 | 429 | 374 | 422 | 181 | 369 | 347 | 120 | 145 | 175 | 167 | 226 | 405 | 211 | 350 | 391 |
| Endoplasmic Reticulum | 3 | 2 | 1 | 0 | 0 | 1 | 1 | – | 1 | 1 | 0 | 1 | 1 | 1 | 0 | 5 | 5 | 9 | 1 | 0 | 0 | 1 | 7 | 2 |
| Endosome | 0 | 0 | 1 | 0 | 0 | 0 | 3 | – | 0 | 2 | 4 | 1 | 0 | 0 | 1 | 0 | 0 | 2 | 4 | 2 | 1 | 1 | 1 | 4 |
| Golgi | 3 | 2 | 0 | 1 | 0 | 0 | 1 | – | 0 | 0 | 0 | 0 | 0 | 0 | 1 | 0 | 0 | 2 | 3 | 3 | 1 | 0 | 2 | 0 |
| Mitochondria | 2 | 1 | 0 | 6 | 7 | 66 | 29 | – | 155 | 110 | 158 | 183 | 1 | 1 | 0 | 1 | 2 | 5 | 1 | 2 | 3 | 0 | 2 | 2 |
| Nucleus | 1 | 2 | 1 | 1 | 1 | 4 | 11 | – | 13 | 18 | 5 | 14 | 1 | 1 | 0 | 9 | 2 | 1 | 0 | 1 | 0 | 0 | 0 | 0 |
| Nuclear Periphery | 0 | 1 | 0 | 0 | 0 | 0 | 0 | – | 2 | 2 | 1 | 1 | 0 | 0 | 0 | 0 | 0 | 0 | 0 | 0 | 0 | 0 | 0 | 0 |
| Nucleolus | 0 | 0 | 0 | 0 | 0 | 0 | 1 | – | 2 | 1 | 2 | 0 | 0 | 0 | 0 | 0 | 0 | 0 | 0 | 0 | 0 | 0 | 0 | 1 |
| Peroxisomes | 0 | 0 | 0 | 0 | 0 | 0 | 0 | – | 0 | 0 | 0 | 0 | 0 | 0 | 0 | 0 | 0 | 0 | 0 | 0 | 0 | 0 | 0 | 0 |
| SpindlePole | 0 | 0 | 0 | 0 | 0 | 0 | 2 | – | 1 | 2 | 0 | 2 | 0 | 0 | 0 | 0 | 0 | 0 | 0 | 0 | 1 | 0 | 4 | 2 |
| Vac/Vac Membrane | 2 | 4 | 6 | 7 | 27 | 11 | 50 | – | 56 | 57 | 38 | 31 | 1 | 2 | 5 | 5 | 6 | 5 | 7 | 9 | 0 | 1 | 1 | 0 |
| Unique Cell Count | 178 | 247 | 428 | 283 | 349 | 343 | 483 | 562 | 550 | 503 | 588 | 184 | 372 | 350 | 128 | 150 | 182 | 193 | 253 | 424 | 222 | 389 | 418 | |
| Labelled Cell Count | 181 | 251 | 438 | 293 | 372 | 396 | 536 | 671 | 630 | 593 | 679 | 185 | 375 | 356 | 146 | 166 | 203 | 193 | 253 | 424 | 222 | 389 | 418 | |
Yeast GFP Assignment
Protein Abundance
| Screen | WT1 | WT2 | WT3 | RAP60 | RAP140 | RAP220 | RAP300 | RAP380 | RAP460 | RAP540 | RAP620 | RAP700 | HU80 | HU120 | HU160 | rpd3Δ_1 | rpd3Δ_2 | rpd3Δ_3 | AF100 | AF140 | AF180 |
|---|---|---|---|---|---|---|---|---|---|---|---|---|---|---|---|---|---|---|---|---|---|
| Mean Cell GFP Intensity (1e-4) | 6.3 | 6.6 | 6.5 | 6.1 | 6.8 | 4.9 | 5.7 | – | 5.0 | 5.3 | 5.0 | 5.0 | 6.7 | 6.9 | 7.2 | 8.2 | 8.3 | 8.4 | 5.9 | 6.4 | 6.3 |
| Std Deviation (1e-4) | 0.9 | 1.1 | 1.1 | 1.6 | 1.5 | 1.5 | 1.8 | – | 1.4 | 1.2 | 1.4 | 0.9 | 1.0 | 1.2 | 1.7 | 1.1 | 1.2 | 1.5 | 1.1 | 2.1 | 1.8 |
| Intensity Change (Log2) | – | – | – | -0.09 | 0.07 | -0.4 | -0.18 | – | -0.38 | -0.3 | -0.36 | -0.38 | 0.05 | 0.09 | 0.16 | 0.33 | 0.36 | 0.37 | -0.14 | -0.02 | -0.04 |
Localization Change
| Localization | RAP60 | RAP140 | RAP220 | RAP300 | RAP380 | RAP460 | RAP540 | RAP620 | RAP700 | HU80 | HU120 | HU160 | rpd3Δ_1 | rpd3Δ_2 | rpd3Δ_3 |
|---|---|---|---|---|---|---|---|---|---|---|---|---|---|---|---|
| Cortical Patches | 0 | 0 | 0 | 0 | – | 0 | 0 | 0 | 0 | 0 | 0 | 0 | 0 | 0 | 0 |
| Bud | 0 | 0 | 0 | 0 | – | 0 | 0 | 0 | 3.1 | 0 | 0 | 0 | 0 | 0 | 0 |
| Bud Neck | 0 | 0 | 0 | 0 | – | 0 | 0 | 0 | 0 | 0 | 0 | 0 | 0 | 0 | 0 |
| Bud Site | 0 | 0 | 0 | 0 | – | 0 | 0 | 0 | 0 | 0 | 0 | 0 | 0 | 0 | 0 |
| Cell Periphery | 0 | 0 | 0 | -0.2 | – | 0 | 0 | -0.9 | -0.1 | 0 | 0 | 0 | 0 | 0 | 0 |
| Cytoplasm | -0.7 | -2.3 | -5.2 | -5.9 | – | -9.9 | -9.5 | -10.5 | -11.3 | -0.2 | 0.8 | 0.7 | -3.1 | -1.5 | -1.9 |
| Endoplasmic Reticulum | 0 | 0 | 0 | 0 | – | 0 | 0 | 0 | 0 | 0 | 0 | 0 | 0 | 0 | 0 |
| Endosome | 0 | 0 | 0 | 0 | – | 0 | 0 | 0 | 0 | 0 | 0 | 0 | 0 | 0 | 0 |
| Golgi | 0 | 0 | 0 | 0 | – | 0 | 0 | 0 | 0 | 0 | 0 | 0 | 0 | 0 | 0 |
| Mitochondria | 0 | 0 | 9.5 | 5.2 | – | 11.8 | 9.8 | 12.7 | 12.7 | 0 | 0 | 0 | 0 | 0 | 0 |
| Nucleus | 0 | 0 | 0 | 2.7 | – | 2.7 | 3.4 | 0 | 2.8 | 0 | 0 | 0 | 0 | 0 | 0 |
| Nuclear Periphery | 0 | 0 | 0 | 0 | – | 0 | 0 | 0 | 0 | 0 | 0 | 0 | 0 | 0 | 0 |
| Nucleolus | 0 | 0 | 0 | 0 | – | 0 | 0 | 0 | 0 | 0 | 0 | 0 | 0 | 0 | 0 |
| Peroxisomes | 0 | 0 | 0 | 0 | – | 0 | 0 | 0 | 0 | 0 | 0 | 0 | 0 | 0 | 0 |
| SpindlePole | 0 | 0 | 0 | 0 | – | 0 | 0 | 0 | 0 | 0 | 0 | 0 | 0 | 0 | 0 |
| Vacuole | 1.0 | 4.4 | 1.7 | 5.6 | – | 5.5 | 5.7 | 4.4 | 3.3 | 0 | 0 | 0 | 0 | 0 | 0 |
External localization resources
Images






























Protein Concentration and Protein Localization Data
| R1 | R2 | R3 | ||||||||||||||||
|---|---|---|---|---|---|---|---|---|---|---|---|---|---|---|---|---|---|---|
| G1 Pre-START | G1 Post-START | S/G2 | Metaphase | Anaphase | Telophase | G1 Pre-START | G1 Post-START | S/G2 | Metaphase | Anaphase | Telophase | G1 Pre-START | G1 Post-START | S/G2 | Metaphase | Anaphase | Telophase | |
| Concentration | 1.2965 | 1.9084 | 1.7565 | 1.5865 | 1.2326 | 1.3622 | 2.8255 | 3.532 | 3.5134 | 2.7865 | 2.8825 | 3.1189 | 4.8785 | 6.2656 | 5.8207 | 5.8546 | 6.1073 | 5.8163 |
| Actin | 0.0286 | 0.0023 | 0.011 | 0.0148 | 0.0389 | 0.0128 | 0.06 | 0.001 | 0.0161 | 0.0053 | 0.0212 | 0.0052 | 0.0221 | 0.0004 | 0.0201 | 0.0008 | 0.0014 | 0.0004 |
| Bud | 0.0008 | 0.0041 | 0.0005 | 0.0352 | 0.0007 | 0.0002 | 0.0014 | 0.0012 | 0.0015 | 0.0023 | 0.0151 | 0.0005 | 0.0001 | 0.0001 | 0.0002 | 0.0001 | 0.0001 | 0 |
| Bud Neck | 0.0008 | 0.0001 | 0.0002 | 0.0005 | 0.0008 | 0.0024 | 0.0067 | 0.0002 | 0.0007 | 0.0005 | 0.0005 | 0.0011 | 0.0005 | 0.0001 | 0.0032 | 0.0003 | 0.0004 | 0.0005 |
| Bud Periphery | 0.0008 | 0.0016 | 0.0003 | 0.0154 | 0.001 | 0.0002 | 0.0018 | 0.0006 | 0.0014 | 0.0027 | 0.0191 | 0.0005 | 0.0001 | 0 | 0.0003 | 0 | 0.0001 | 0 |
| Bud Site | 0.0028 | 0.0062 | 0.0009 | 0.0028 | 0.0045 | 0.0001 | 0.0151 | 0.0019 | 0.006 | 0.002 | 0.0019 | 0.0009 | 0.0003 | 0.0003 | 0.001 | 0.0002 | 0.0004 | 0 |
| Cell Periphery | 0.0001 | 0.0001 | 0.0001 | 0.0005 | 0.0001 | 0 | 0.0004 | 0.0001 | 0.0002 | 0.0001 | 0.0003 | 0 | 0.0001 | 0 | 0.0002 | 0.0001 | 0 | 0 |
| Cytoplasm | 0.7676 | 0.8323 | 0.9107 | 0.7429 | 0.7961 | 0.8645 | 0.6571 | 0.9103 | 0.8075 | 0.752 | 0.639 | 0.8836 | 0.8262 | 0.8593 | 0.867 | 0.8753 | 0.7589 | 0.8936 |
| Cytoplasmic Foci | 0.0171 | 0.0129 | 0.0082 | 0.0124 | 0.0214 | 0.0086 | 0.0255 | 0.0088 | 0.0103 | 0.028 | 0.0151 | 0.0131 | 0.0028 | 0.004 | 0.0032 | 0.0065 | 0.0266 | 0.0033 |
| Eisosomes | 0.0001 | 0 | 0 | 0.0001 | 0.0002 | 0.0001 | 0.0004 | 0 | 0.0002 | 0 | 0.0002 | 0.0001 | 0.0002 | 0 | 0.0002 | 0 | 0 | 0 |
| Endoplasmic Reticulum | 0.0087 | 0.003 | 0.0053 | 0.0036 | 0.0076 | 0.0028 | 0.0071 | 0.0013 | 0.0035 | 0.002 | 0.0044 | 0.0038 | 0.0098 | 0.0029 | 0.0028 | 0.0057 | 0.0046 | 0.0029 |
| Endosome | 0.0264 | 0.0041 | 0.0039 | 0.0117 | 0.0263 | 0.012 | 0.0305 | 0.0026 | 0.0123 | 0.0044 | 0.0329 | 0.0079 | 0.0079 | 0.0014 | 0.0034 | 0.0021 | 0.012 | 0.0013 |
| Golgi | 0.0033 | 0.0001 | 0.0014 | 0.01 | 0.0099 | 0.0033 | 0.0088 | 0.0008 | 0.0052 | 0.0047 | 0.0232 | 0.0042 | 0.0012 | 0.0001 | 0.0024 | 0.0001 | 0.0016 | 0.0001 |
| Lipid Particles | 0.0018 | 0.0004 | 0.0014 | 0.0006 | 0.0051 | 0.0004 | 0.0162 | 0 | 0.0027 | 0.0022 | 0.0292 | 0.0038 | 0.0004 | 0.0001 | 0.0006 | 0 | 0.0062 | 0 |
| Mitochondria | 0.0021 | 0.0002 | 0.0004 | 0.0135 | 0.0046 | 0.0059 | 0.0053 | 0.0006 | 0.0053 | 0.0008 | 0.0182 | 0.0064 | 0.0004 | 0.0001 | 0.0014 | 0.0001 | 0.0003 | 0.0001 |
| None | 0.0942 | 0.1225 | 0.0466 | 0.1182 | 0.0443 | 0.0741 | 0.1233 | 0.0627 | 0.1046 | 0.1577 | 0.1566 | 0.0456 | 0.1123 | 0.1265 | 0.0883 | 0.0997 | 0.1299 | 0.0878 |
| Nuclear Periphery | 0.0132 | 0.0017 | 0.0021 | 0.0047 | 0.015 | 0.0019 | 0.0117 | 0.0009 | 0.0031 | 0.0012 | 0.0044 | 0.0035 | 0.0042 | 0.001 | 0.001 | 0.0019 | 0.0022 | 0.001 |
| Nucleolus | 0.0005 | 0.0002 | 0.0001 | 0.0002 | 0.0003 | 0.0001 | 0.0007 | 0 | 0.0004 | 0.0001 | 0.0002 | 0.0001 | 0 | 0 | 0.0001 | 0 | 0.0008 | 0 |
| Nucleus | 0.017 | 0.0034 | 0.0034 | 0.0061 | 0.0044 | 0.0076 | 0.0057 | 0.0032 | 0.007 | 0.0033 | 0.0049 | 0.0088 | 0.0096 | 0.0024 | 0.0029 | 0.0043 | 0.0026 | 0.0073 |
| Peroxisomes | 0.0023 | 0.0001 | 0.0011 | 0.0027 | 0.0122 | 0.0002 | 0.011 | 0.002 | 0.0047 | 0.0256 | 0.0074 | 0.0066 | 0.0001 | 0.0001 | 0.0003 | 0.0002 | 0.0027 | 0.0001 |
| Punctate Nuclear | 0.0063 | 0.0012 | 0.0012 | 0.0008 | 0.0027 | 0.0014 | 0.0068 | 0.0006 | 0.0059 | 0.0039 | 0.0037 | 0.0029 | 0.0006 | 0.0006 | 0.0004 | 0.0016 | 0.048 | 0.0012 |
| Vacuole | 0.0042 | 0.0033 | 0.0011 | 0.0025 | 0.0021 | 0.0012 | 0.0029 | 0.0009 | 0.0012 | 0.0009 | 0.0015 | 0.0008 | 0.0007 | 0.0005 | 0.0007 | 0.0008 | 0.0011 | 0.0003 |
| Vacuole Periphery | 0.0015 | 0.0002 | 0.0002 | 0.001 | 0.0019 | 0.0004 | 0.0015 | 0.0002 | 0.0004 | 0.0002 | 0.0009 | 0.0007 | 0.0003 | 0.0001 | 0.0003 | 0.0001 | 0.0002 | 0.0001 |
Sequencing Data
| R1 | R2 | |||||||||
|---|---|---|---|---|---|---|---|---|---|---|
| G1 Post-START | S/G2 | Metaphase | Anaphase | Telophase | G1 Post-START | S/G2 | Metaphase | Anaphase | Telophase | |
| Gene Expression | 40.6785 | 31.8186 | 7.8703 | 22.5367 | 42.8524 | 42.35 | 25.2778 | 17.0608 | 20.24 | 34.8731 |
| Translational Efficiency | 1.3119 | 0.9155 | 2.7194 | 1.5699 | 0.8261 | 1.3089 | 1.168 | 1.4929 | 1.602 | 1.2751 |
Hit Data
| Dataset | Hit |
|---|---|
| Protein Concentration | ✘ |
| Protein Localization | ✘ |
| Gene Expression | ✔ |
| Translational Efficiency | ✘ |
Endocytosis
| Temp | Actin Patch (Sac6-tdTomato) | Cortical Patch (Sla1-GFP) | Late Endosome (Snf7-GFP) | Vacuole (Vph1-GFP) |
|---|---|---|---|---|
| 37℃ | ||||
| RT |
Cell Cycle Omics
CYCLoPs (Cdc8-GFP)
| Gene / Allele | Actin Patch (Sac6-tdTomato) | Cortical Patch (Sla1-GFP) | Late Endosome (Snf7-GFP) | Vacuole (Sac6-tdTomato) |
|---|
| Gene | Images |
|---|
| Gene | Images |
|---|
Images are not yet available
Images are not yet available